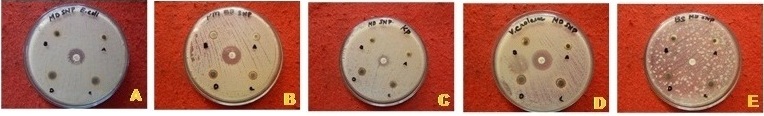

Int J Pharm Pharm Sci, Vol 6, Issue 7, 395-399Original Article
LARVICIDAL AND ANTIBACTERIAL EFFICACY OF GREEN SYNTHESISED SILVER NANOPARTICLES USING MELIA DUBIA
JAGADEESAN KARTHIKEYAN*, KAMALANATHAN MULLAI NILA, GEORGE THOOYAVAN, ELANGOVAN VIMALKUMAR
Department of Zoology, Presidency College (Autonomous), Chennai 600005
Email: j_karthikeyan@hotmail.com
Received: 30 May 2014 Revised and Accepted: 11 Jul 2014
ABSTRACT
Objectives: Plant extracts seems to be a better alternative to control pathogenic organisms due to the presence of many bioactive compounds. In addition, the plant mediated synthesized silver nanoparticles also have important applications in the field of biology, the present study aims to study the activity of AgNP’s (Silver Nanoparticles) synthesized using the leaves of Melia dubia against the 4th instar larvae of Culex quinquefasciatus and pathogenic microbes
Methods: The synthesized AgNP’s were characterized by UV-Vis spectrum, Scanning Electron Microscopy (SEM), Energy dispersive X-ray spectroscopy(EDX) and Fourier Transform Infrared Spectroscopy (FTIR). The 4th instar larvae of Culex quinquefasciatus were exposed to different concentrations of aqueous leaf extract (5, 10, 15, 20, 25ppm) and Silver nanoparticles (1, 2, 3, 4, 5 ppm) for 24 hours period. The antibacterial activity was measured by disk diffusion method against Bacillus subtilis, Proteus mirabilis, Klebseilla pneumoniae, Escherichia coli, and Vibrio cholerae.
Results: The observations reveal that the silver nanoparticles synthesized using Melia dubia leaves were more effective than the crude leaf extract of the plant over Culex quinquefasciatus and microbes tested. Moreover, the results of metabolites also revealed that the AgNP’s significantly altered the carbohydrates and protein level in the 4th instar larvae of Culex quinquefasciatus.
Conclusion: The larvicidal and bactericidal activities are due to various phytoconstituents coated with the nanoparticles. It is further inferred from the results that the use of AgNP’s for the control of targeted vectors is to eradicate disease transmitting mosquitoes as well as to control microbes.
Keywords: Melia dubia, Silver Nanoparticles, FTIR, SEM, EDX, Antibacterial activity, Larvicidal activity.
INTRODUCTION
Silver has been used in ancient Indian Medical System (Ayurveda) as therapeutic agent for many diseases. Silver ions and silver based compounds show strong biocidal activity against many bacterial species[1]. Nanoparticles are more interesting due to their effectiveness, minimal toxicity and side effects. Nanotechnology enabled the synthesis of pure silver as nanoparticles which are more efficient than silver ions[2]. Nanoparticles with high surface area to volume ratio and with unique chemical and physical properties are better alternatives against disease causing organisms[3]. Gold and silver nanoparticles can be used as growth inhibitors against E.coli and S. aureus[4]. Plant mediated synthesis of nanoparticles was considered to be more effective and environmental friendly when compared to synthetic methods[5]. Green synthesis of silver nanoparticles doesn’t require the use of toxic chemicals, high pressure and temperature etc., for the reduction process.
Lymphatic filariasis commonly known as elephantiasis is a neglected tropical disease, the acute episode of the disease cause temporary disability[6]. About 120 million people in 81 countries have been infected by filariasis and 1.34 billion people were estimated to be at the risk of infection (WHO). Culex quinquefasciatus is an important vector of lymphatic filariasis and these mosquitoes are known to transmit deadly diseases such as encephalitis, Japanese encephalitis etc., Chemical pesticides are used conventionally to control the mosquitoes. Frequent use of synthetic insecticides results in the development of resistance among vectors, further these insecticides also become non-biodegradable toxic residues, resulting in the contamination of environment. [7,8].
Plant extracts were effective against various insects and the potential action over the mosquito population may be due to the presence of various bioactive compounds[9,10]. However, the mechanism of action of the bioactive compound was not fully known.
Development of resistance against antibiotics by the pathogenic microorganisms paves way for the invention of new antimicrobial agent with different mode of action against the microbes. Silver nanoparticles have an advantage over the conventional antibiotics[11]. Silver nanoparticles have considerable antifungal activity when compared to antifungal drugs[12].
Melia dubia commonly known as Malaivembu in Tamil is a member of the family Meliaceae. Different parts of the plant has been studied for its medicinal properties such as antiviral activity, antimicrobial, and antifeedant activity. Melia dubia is valued for its quality termite and fungus resistant timber [13]. The fruits of M. dubia were used in folia medicine as an anthelmintic, astringent and in the treatment of colic disorders[14].
The aqueous extract of leaves control the fruit rotting in apple[15]. The plant has great potential to resist the pest attack[16]. The present study was carried out to assess the larvicidal and antibacterial efficacy of silver nanoparticles synthesized using aqueous leaf extract of Melia dubia.
MATERIALS AND METHODS
Green synthesis of silver nanoparticles:
Fresh and disease free leaves of Melia dubia were collected from Presidency College Campus and identified with the help of Post graduate and Research Department of Plant biology and Biotechnology. The disease free leaves were thoroughly washed, finely chopped and used for the synthesis of silver nanoparticles. 5grams of leaves were boiled with 100ml of de-ionized water and filtered. 10ml of filtrate was added to 90ml of 1mM aqueous silver nitrate for the reduction of silver ions. The bioreduction of silver ions was observed using UV absorption at 430 nm at room temperature. UV-Vis spectra were recorded as a function of reaction time on the UV spectrophotometer.
Characterization of Silver nanoparticles
Silver nanoparticles exhibit an intense brown color due to the surface plasmon resonance, which results from collective oscillations of their conduction band electrons in response to electromagnetic waves. Under the UV region, Silver nanoparticles give a characteristic absorbance band due to the excitation mode of their surface plasmons which is dependent on the nanoparticle size. The bioreduction was monitored by periodic sampling of aliquots of the aqueous component and by measuring the UV-Vis spectrum.
The nanoparticles showed a size of 30-50 nm. UV–Vis spectrum of Ag- nanoparticles showed maximum absorbance at 420 nm. Hence, absorbance peaks can be used as tools to predict particle size and stability. Smaller silver nanoparticles will have an absorbance maximum of 420 nm which increases with size and disappears when particle size falls outside nanodimensions. To study the optical properties of our silver nanoparticles, the absorbance maximum of silver nanoparticles in the sample was measured. After the confirmation of UV-Visible spectrum for the presence of silver nanoparticles the solution was centrifuged at 15,000RPM for 30 minutes so that the particles precipitated. The supernatant was discarded and the pellets were allowed to dry and the size of the particles were characterized by Scanning Electron Microscopy (SEM), EDX and Fourier Transform Infrared Spectroscopy (FTIR).
Mosquito larvicidal bioassay
Standard methods for testing biologically synthesized nanoparticles and the susceptibility of mosquito larvae to nanoparticles was performed as stipulated by WHO. The larvicidal bioassay were performed at room temperature of 27 ±1°C. The larvae of Culex quinquefasciatus were collected from stagnant water area in coovam river, Chennai. The larvae were identified by using the keys[17]. The larvicidal activity of plant mediated synthesized Silver nanoparticles were performed by placing 20 mosquito larvae in 200ml of sterilized distilled water. From the stock solution different concentrations of Silver nanoparticles (1, 2, 3, 4, 5 ppm) and different concentrations of aqueous leaf extracts(5,10,15,20 and 25ppm) were prepared and the larvicidal activity was carried out.
Estimation of metabolites
Biochemical parameters were studied using the following methods, total protein content was determined following Lowry’s method[18]. The amount of total carbohydrates present in the Trichloro Acetic Acid (TCA) soluble tissue extracts were estimated by Oligo and polysaccharide sensitive Phenol-Sulphuric acid method[19].
Antibacterial activity
Antibacterial activity was evaluated using the disk diffusion method. Disk diffusion assay is used widely to determine the anti-bacterial activity. The technique works well with defined inhibitors[20]. Sterile disks (HiMedia) were soaked separately with 20 μl of varying concentrations of 1, 2, 3, 4µg/ml of green synthesized silver nanoparticles. These discs were placed on Mueller-Hinton agar plates, previously swabbed with the target bacterial isolate at a concentration of 106 CFU/ml. In one disc, the antibiotic ampicilline was added as negative control to determine possible inhibitory activity. This preparation was incubated for a period of 24 h at 30°C. Antibacterial activity was defined as the diameter (mm) of the clear inhibitory zone formed around the disks.
RESULTS
UV-Vis. spectroscopical analysis
Freshly collected Melia dubia leaves were used as a reducing agent of silver for the synthesis of silver nanoparticles. 10ml of the filtrate was treated with 90ml of 1mM silver nitrate solution and incubated in dark condition at room temperature. Appearance of brownish yellow colour indicates the formation of silver nanoparticles. It is further confirmed by surface Plasmon resonance peak in the UV-Visible absorption spectra with a absorption peak at 424nm, the synthesized nanoparticles were characterized using scanning electron microscopy for the size of the nanoparticles (Figure 3) reveals the presence of nanoparticles in the size range of 45nm – 65nm.

Fig. 1: UV –Vis spectrum of green synthesized silver nanoparticle
Energy dispersive X –Ray spectroscopy analysis
Elemental analysis of silver nanoparticles were performed using Energy Dispersive X-ray Spectroscopy (EDX) equipped on SEM. The EDX spectrum (Figure 2) shows the presence of pure silver with the peaks.

Fig. 2: EDX Spectroscopic analysis of Silver Nanoparticles

Fig. 3: Scanning electron microscopic images of synthesized nanoparticles using aqueous leaf extract of melia dubia
Fourier transform infrared spectroscopy analysis
Fourier Transform Infrared Spectroscopic analysis of the synthesized silver nanoparticles (Figure 4) reveals the presence of various peaks at 3417cm-1,2922cm-1, 2522 cm-1, 1747cm-1,1607cm-1, 1544cm-1, 1384 cm-1, and 1047cm -1. The broad spectrum observed at 3417cm-1 can be assigned to the N-H stretching frequency arising from the peptide linkage present in the protein part of the extract. The strong absorption at 1744cm-1 is due to the carbonyl stretching vibration of the acid groups present in the extract. The absorbance bands at 2922 cm-1, 1607cm-1, 1384cm-1, and 1047cm-1 was associated with respect to the stretched vibrations of alkanes C-H conjugated with carboxylic acid. Bending of N-H primary amines and the scissoring mode of methylene tail CH3R. Peak observed at the 1047cm-1 represents C-N and the presence of polyphenols. The absorption spectra at about 1544cm-1 resulting from stretching vibration of C=C. The peak at around 1540cm-1 indicates the amide1 bonds of proteins. The amide 1 bond derived from the protein are the capping legends of the nanoparticles[21].

Fig. 4: FTIR Spectroscopy analysis of silver nanoparticles synthesized using leaves of Melia dubia
Larvicidal activity of Silver Nanoparticles
The larvicidal activity of aqueous leaf extracts of Melia dubia and silver nanoparticles synthesized using Melia dubia leaves were tested against 4th instar larvae of the filarial vector Culex quienquefasciatus. The 4th instar larvae was isolated and treated with different concentration of aqueous leaf extract (5,10,15,20,25ppm) and green synthesized silver nanoparticles (1,2,3,4,5ppm). Highest mortality was observed with the synthesized silver nanoparticles treated group after 24 hours when compared to aqueous leaf extract of Melia dubia.
The LC50 and LC90 values were (11.27ppm and 22.94ppm) respectively with reference to aqueous leaf extract. In silver nanoparticles treated group the LC50 value is 2.27ppm and LC90 value of 4.53ppm. Table 1 reveals the percentage of mortality of about 72.81% after 72 hrs of post exposure to 5ppm concentration of aqueous extracts of Melia dubia, 95.12% mortality in the 4th instar larvae was observed after 72 hrs with the concentration of 25ppm. However, the green synthesized silver nanoparticles were more effective against the Culex larvae as the percentage of mortality recorded was 86.88% after 24 hrs of post exposure at 5ppm concentration (Table 2).
The 4th instar larvae of Culex were treated with LC50 doses of 2.27ppm dosage of silver nanoparticles and 11.27ppm dose of aqueous leaf extract for a period of 24 hours. The carbohydrate level increases from 35.75 ± 0.326 mg/gm in control to 55.11 ± 0.104 and 55.23 ± 1.337 mg/gm in silver nanoparticles treated and aqueous leaf extract treated 4th instar larvae of Culex quinquefasciatus. Total protein content decreases from 24.14 ± 1.701 mg/gm to 16.78 ± 2.471mg/gm after silver nanoparticle treatment (Table 3). However, in aqueous leaf extract treated group no changes were observed with reference to total protein content.
Table 1: Larvicidal activity (%) of different concentrations of aqueous extract of leaves of Melia dubia on early 4th instar larvae of Culex quinquefasciatus
| Concentration (ppm) | Percentage of Mortality (Mean ± S.E) | ||
| 24 Hrs | 48Hrs | 72Hrs | |
| 5 | 31.33 ± 0.199 | 56.55 ± 0.196 | 72.81 ± 0.345 |
| 10 | 35.47 ± 0.135 | 65.18 ± 0.069 | 78.01 ± 0.391 |
| 15 | 53.13 ± 0.180 | 71.25 ± 0.148 | 91.07 ± 0.420 |
| 20 | 58.31 ±0.127 | 78.36 ± 0.159 | 91.69 ± 0.307 |
| 25 | 61.79 ± 0.149 | 86.66 ± 0.176 | 95.12 ± 0.135 |
Table 2: Larvicidal efficacy (%) of green synthesized Silver Nanoparticles on early 4th instar larvae of Culex quinquefasciatus
| Concentration (ppm) | Percentage of Mortality (Mean ± S.E) | ||
| 24 Hrs | 48Hrs | 72Hrs | |
| 1 ppm | 24.53 ± 0.206 | 33.09 ± 0.216 | 65.51 ± 0.211 |
| 2 ppm | 33.25 ± 0.121 | 51.31 ± 0.219 | 72.03 ± 1.448 |
| 3 ppm | 70.43 ± 0.235 | 81.11 ± 0.301 | 83.27 ± 0.152 |
| 4 ppm | 76.60 ± 0.288 | 90.73 ± 0.235 | 91.62 ± 0.191 |
| 5 ppm | 86.88 ± 0.125 | 92.10 ± 0.204 | 96.70 ± 0.348 |
The impact of aqueous extract and silver nanoparticles synthesized from the leaves of Melia dubia over the growth of the larvae were analyzed with biochemical metabolic processes.
Table 3: Concentration of protein and carbohydrates of 4th instar larvae of Culex quinquefasciatus after the exposure to silver nanoparticles and aqueous extract of Melia dubia (Mean ± S.E)
| Control | SNP Treated | Aqueous Extract treated | |
| Protein | 24.14 ± 1.701 | 16.78 ± 2.471 | 20.56 ± 0.144 |
| Carbohydrate | 35.75 ± 0.326 | 55.11 ± 0.104 | 55.23 ± 1.337 |
Antibacterial Activity
The observations given in Table 4 reveals the dose dependent increase in the bactericidal activity of green synthesized nanoparticles. Ampicillin impregnated disks were used as positive control. Green synthesized silver nanoparticles were tested for its antibacterial efficacy against gram positive and gram negative bacteria. The minimum inhibition concentration (MIC) was observed between 3µg/ml - 7µg/ml. The pure cultures of Bacillus subtilis, E.coli, Proteus mirabilis, Klebseilla pneumonia, Vibreo cholerae were used for the study. The diameter of inhibition zone around the SNP impregnated disks were recorded (Figure 5), the zone of inhibition in gram positive bacteria Bacillus subtilis (9mm), and in gram negative bacteria the inhibition zones were of 9,9,7,11mm with reference to Klebseilla pneumonia, Proteus mirabilis E.coli and Vibrio cholerae, respectively.
DISCUSSION
Medicinal plants have been used to treat many diseases. In the present study an evaluation of the Larvicidal and bactericidal efficacy of the green synthesized silver nanoparticles was studied. Silver nanoparticles synthesized using aqueous leaf extract of Melia dubia as reducing agent was characterized using Scanning Electron Microscopy, EDX, and FTIR spectroscopy.
Fig. 5: Antibacterial activity of green synthesized silver nanoparticles against (A) Escherichia coli, (B) Proteus mirabilis (C) Klebseilla pneumoniae (D) Vibrio cholerae (E) Bacillus subtilis
Table 4: Shows antibacterial activity of green synthesized silver nanoparticles (mm)
| Bacterial Species | 1µg/ml | 2µg/ml | 3µg/ml | 4µg/ml | Ampicillin |
| Proteus mirabilis | 7 | 8 | 8 | 9 | 17 |
| Klebseilla pneumoniae | - | 7 | 7 | 9 | 12 |
| Escherichia coli | - | - | 7 | 8 | 13 |
| Vibreo cholerae | 7 | 8 | 9 | 11 | 17 |
| Bacillus subtilis | - | - | 9 | 9 | --- |
The broad peak at 420 nm of the UV visible spectrum shows the presence of silver particles[22]. As the reaction time increases the peak area also increases, the increased peak area was due to the reduction of silver ions by biomolecules[23]. It is observed from the FTIR spectrum that active compounds are present in the extract and also reveals that specific bonds correspond to reacting molecules. The peak absorbed at 1544cm-1with the stretching vibrations of C=C shows the presence of amide -1 bands of protein.
The sharp absorption peak at 1747cm-1was assigned to C=O, stretching vibration in the carbonyl compounds may be characterized by the presence of high content of terpenoids and flavonoids. The narrow peak at 1047cm-1corresponds to C-N stretching vibrations of aliphatic amines or alcohols/phenols, representing the presence of polyphenols[24].
The findings of the present study proves that the silver nanoparticles shows maximum larvicidal activity against C. quinquefasciatus. The increase in total carbohydrate level in the tested groups could be due to the stress induced by these extracts as well as silver nanoparticles on the 4th instar larvae of C. quinquefasciatus. Increase in glucose level due to insecticidal stress [25]. Level of total protein in the nanoparticle treated group significantly decreased to 48.35% from the control values. The reduction in total protein of 63.13% was recorded with Anopheles larvae after treatment with Artemisia annua[26]. The reduction in the protein level may be due to the binding of silver nanoparticles with the sulphur containing protein or to phosphorous containing compounds like DNA leading to the denaturation of some cell organelles and enzymes[27].
The antibacterial activity of silver nanoparticles was more pronounced against the gram positive and gram negative bacteria. The gram positive bacteria possess a thick cell wall with high amount of peptidoglycan and the outer membrane of gram negative bacteria comprises of lipo polysaccharides, which provides resistance to many antibacterial drugs. However, the green synthesized silver nanoparticles have the potential to penetrate/damage the cell wall of bacteria. The intercellular binding of nanoparticles alters the membranes permeability leading to the death of the organisms[28]. The interaction of silver ions with enzymes of respiratory chain leads to cell death[29], and metabolic pathways[30]. The interaction of the nanoparticles with the sulfur and phosphorus of the DNA can interfere with the replication of DNA which leads to the denaturation of cell organelles and kills the microbes[31]. The present study also proves that intercellular binding of nanoparticles with the cell organelles could be the cause for the inhibition of growth in the microorganisms. The interference is not only by the nanoparticles but also by the bioactive compounds along with the nanoparticles.
CONCLUSION
Melia dubia leaves mediated silver nanoparticles was synthesized and tested for its effect on 4th instar larvae of C. quienquefasciatus and pathogenic microorganisms. Green synthesized silver nanoparticles act as more potent and environment friendly antimicrobial agent when compared to other synthetic nanoparticles, and also act as more potent and environment friendly ecopesticide. The effect of silver nanoparticles on larvicidal, and bactericidal activities is based on the presence of various phytoconstituents present along with nanosilver. Further research may throw light on the specific target drug for the complete eradication of filariasis vectors.
CONFLICT OF INTERESTS
Declared None
ACKNOWLEDGEMENT
The author gratefully acknowledges the University Grants Commission, New Delhi, India, for funding the Major Research Project (41-125/2012(SR)) to carry out this research.
REFERENCES
- Zhao GJ, Stevens SE. Multiple parameters for the comprehensive evaluation of the susceptibility of Escherichia coli to the silver ion. J Bimetals 1998;11:27-32.
- Lara HH, Ayala-Nuñez NV, Ixtepan-Turrent L, Rodriguez-Padilla C. Bactericidal effect of silver nanoparticles against multidrug-resistant bacteria. World J Microbiol Biotechnol 2010;26:615-21.
- Kim JS, Kuk E, Yu KN, Kim JH, Park SJ, Lee HJ, Kim SH, Park YK. Antimicrobial effects of silver nanoparticles. Nanomedicine:nanotechnology. J Biology and Medicine 2007;3(1):95-101.
- Ahmad T, Wani IA, Manzoor N, Ahmed J, Asiri AM. Biosynthesis, structural characterization and antimicrobial activity of gold and silver nanoparticles. J Colloids Surf B Biointerfaces 2013;107(1):227-34.
- Karthikeyan J, Srinivasan PT, Krithika RS, Bavani G. Extracellular synthesis of silver nanoparticles by Menta Piperita (Leaf Broth) and Bacillus subtilis (Culture Supernatant):a comparative study. Int J Nanotechnol 2011;5(1Appl):37-45.
- World Health Organization Lymphatic filariasis Fact sheet No.102 2012.
- Jantan L, YalvemaMF, Ahmed NW, Jamal JA. Insecticidal activities of the leaf oils of eight Cinnamomum species against Aedes aegypti and Aedes albopictus. J Pharm Biol 2005;43:526-32.
- Yang YC, Lee SG, Lee HK, Kim Mk, Lee SH, Lee HS. A piperidine amide extracted from Piper longum L. fruit shows activity against Aedes aegypti mosquito larvae. J Agri Food Chem 2002;50:3765-67.
- Cheng SS, Liu JY, Tsai KH, Chen WJ, Chang ST. Chemical composition and mosquito Larvicidal activity of essential oils from leaves of different Cinnomomum osmophloeum provenances. J Agric Food Chem 2004;52:4395-400
- Govindarajan M. Larvicidal efficacy of Ficus benghalensis L. plant leaf extracts against Culex quinquefasciatus Say, Ades aegyptiL and Anopheles stephensi L.(Diptera:Culicidae). J Eur Rev Med Pharmacol Sci 2010;14:107-11.
- Savithramma M, Linga Rao M, Rukmini K, Suvarnalatha Devi P. Antimicrobial activity of Silver nanoparticles synthesized by using Medicinal Plants. Int J Chem Tech Res 2011;3:1394-1402.
- Nasrollahi A, Pourshamsian Kh, Mansourkiaee P. Antifungal activity of silver nanoparticles of some fungi. Int J Nano Dim 2011;1(3):233-9.
- Suprapti S, Djarwanto, Hudiansyah. The resistance of five wood species against several wood destroying fungi. J Peneli Hasil Hutan 2004;22(4):239-46.
- Kiritkar KR Basu BD. Indian Medicinal Plants (eds Blatter, E., Caicus,J.F. and Mhaskar,K.S.) International Book Distributers, Dehradun. Vol.1, pp 545-46. 1999.
- Sharma IM, Bhardwaj SS. Use of plant extracts and yeast antagonists in the management of storage scab and rots of apple fruits. J Biol Control 2000;14:17-23.
- Koul O, Multani JS, Singh G, Wahab S. Bioefficacy of toosendanin from Melia dubia (syn.M.azedarach) against gram pod borer, Helicoverpa armigera (Hubne). Current Sci (India) 2002;83:1387-91.
- Reuben R, Tewari SC, Hiriyan J, Akiyama J. Illustrated keys to species of Culex (Culex) associated with Japanese encephalitis in Southeast Asia (Diptera:Culicidae). J Mosquito Systematics 1994;26 (2):75-96.
- Lowry OH, Rosebrough NJ, Farr AL, Randall RJ. Protein Measurement with the. J Folin Phenol Reagent 1951;193(1):265-75.
- Du Bois M, Gilles K, Hamilton J, Rebers P, Smith F. Colorimetric method for determination of sugars and related substances. J Analytical Chemistry 1956;28(3):350-6.
- Hewitt W, Vincent S. Assay design and evaluation. In Theory and Applications of Microbiological Assay. 1st edn. (Hewitt,W &Vincent,S., Eds) p. 185-211. San Diego Academic Press, 1989.
- Raut RW, Jaya RL, Niranjan K, Vijay DM, Sahebrao BK. Photosynthesis of Silver Nanoparticles Using Gliricidia sepium (Jacq.). J Current Nanoscience 2009;5:117-22.
- Sathishkumar M, Sneha K, Won SW, Cho CW, Kim S, Yun YS. “Cinnamon zeylanicum bark extract and powder mediated green synthesis of nano-crystalline silver particles and its bactericidal activity.” J Colloids and Surfaces B 2009;73:332-8.
- Huang J, Li Q, Sun D, Lu Y, Su Y, Yang X, Wang H, Wang Y, Shao W, He N, Hong J, Chen C. Biosynthesis of silver and gold nanoparticles by novel sundried Cinnamomum camphora leaf. J Nanotechnology 2007;18:104-105.
- Mukherjee P, Roy M, Mandal BP. Green synthesis of highly stabilized nanocrystaline silver particles by a non pathogenic and agriculturally important fungus T. asperellum. J Nanotechnology 2008;19:075103.
- Nath BS, Suresh A, Varma BM, Kumar RPS. Changes in protein metabolism in hemolymph and fat body of the silkworm, Bombyx mori (Lepidoptera:Bombycidae) in response to organophosphorus insecticides toxicity. J Ecotoxicol Environ Safety 1997;36 (2):169-73.
- Sharma P, Mohan L, Dua KK, Srivastava CN. Status of carbohydrate, protein and lipid profile in the mosquito larvae treated with certain phytoextracts. Asian Pacific J Tropical Medicine 2011;301-4.
- Rai M, Yadav A, Gade A. Silver nanoparticles as a new generation of antimicrobials. J Biotechnol Adv 2009;27:76-83.
- Sondi I, Sondi SB. Silver nanoparticles as antimicrobial agent:a case study on E.coli as a model for Gram –negative bacteria. J Colloid Interface Sci 2004;275:177-82.
- Halt KB, Bard AJ. Interaction of silver (I) ions with the respiratory Chain of Escherichia coli:an electrochemical and scanning electrochemical microscopy study of the antimicrobial mechanism of micromolar Ag+. J Biochemistry 2005;44 (39):13214-23.
- Warisnoicharoen W, Hongpiticharoen P, Lawanprasert S. Alteration in Enzymatic function of Human cytochrome P450 by silver nanoparticles. Res J Environ Toxicol 2001;5:58-64.
- Hatchett DW, Henry S. Electrochemistry of sulfur adlayers on the low-index faces of silver. J Phys Chem 1996;100:9854-59.